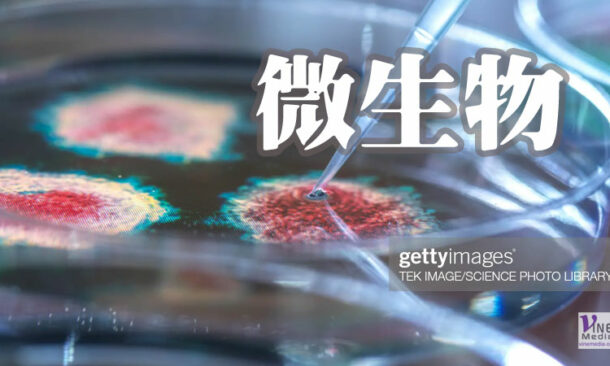

香港 陳永康 2023 …
奇妙的創造
奇妙的創造
香港 陳永康 二十世紀是 …
香港 陳永康 2016 …
香港 陳永康 踏入香港社 …
『1940 年 5 月 …
蜜蜂被譽為數學天才及智慧 …
亞當和夏娃沒有聽從神的囑 …
加拿大聯邦政府正式通過吸 …
二十一世紀新世紀來臨,由 …
在覆蓋地球近 70%表面 …
牠們是生活在海中的生物, …
論任何生物,細胞是它/牠 …
2003 年初,一種新型 …
SARS 是 RNA 病 …
在動物世界,雀鳥(通常是 …
當以色列人在曠野漂流了一 …
相信很多人都曾經到過眼科 …